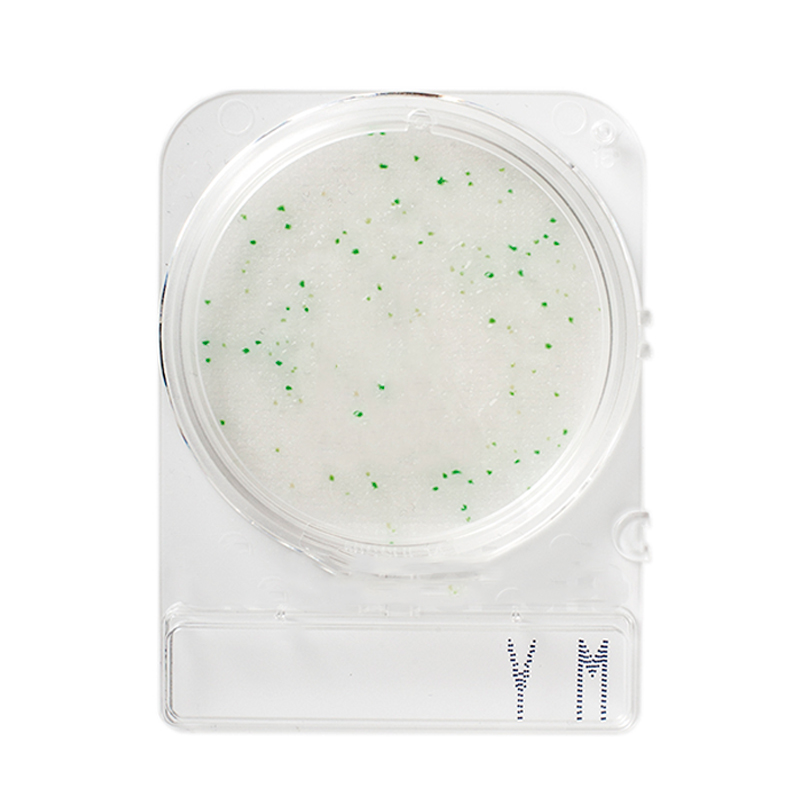

x


Rastreamento de Cargas
(*) Quando o remetente ou o destinatario for pessoa fisica, adicionar "000" (3 zeros) antes do numero do CPF.

(*) Quando o remetente ou o destinatario for pessoa fisica, adicionar "000" (3 zeros) antes do numero do CPF.
Bandeja com 4 compartimentos para teste de mastite subclínica.
Entre em contato conosco atráves de um representante ou envie um e-mail pela aba contato.
Fale conosco